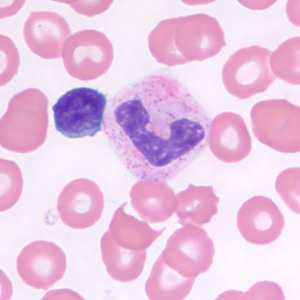
Figure E

Artifacts
[Blood] [Stool] [Tissue]
Epithelial and white blood cells in stool.

Figure A: White blood cells in a trichrome-stained stool smear.

Figure B: Macrophages in a trichrome-stained stool smear.

Figure C: Epithelial cell in a trichrome-stained stool smear.
Yeast and other fungal elements in stool.

Figure A: Yeast in an iodine-stained concentrated wet mount of stool. Yeast in wet mounts may be confused for Giardia.

Figure B: Spore of a morel mushroom. Such spores may be confused for helminth eggs, especially hookworm.

Figure C: Fungal spore in concentrated wet mounts of stool. Such spores may be confused for protozoa such as Giardia or Chilomastix.

Figure D: Fungal spore in concentrated wet mounts of stool. Such spores may be confused for protozoa such as Giardia or Chilomastix.

Figure E: Fungal spore in a wet mount of stool. Such spores may be confused for the cysts of Entamoeba spp.
Pollen grains in stool.

Figure A: Pollen grain in a concentrated wet mount of stool. This grain looks very similar to the fertile egg of Ascaris lumbricoides, although the spine-like structures on the outer layer should separate the two.

Figure B: Possible pollen grain or algal or fungal spore in a concentrated wet mount of stool. Grains like this one resemble the operculated eggs of Clonorchis, Metagonimus and related. These grains are usually smaller than the trematode eggs, however. Image courtesy of the Washington State Public Health Laboratories.

Figure C: Pollen grain in a concentrated wet mount of stool.

Figure D: Pollen grain in a trichrome-stained stool specimen. In this focal plane, the grain looks like the striated egg of Taenia sp. However, notice the lack of refractile hooks.

Figure E: Possible pollen grain or algal or fungal spore, similar to the one in Figure B, but in a trichrome-stained stool specimen. Image courtesy of the Washington State Public Health Laboratories.
Plant material and plant hairs in stool.

Figure A: Plant cell in a concentrated wet mount of stool. Such material can be common in stool and may be confused for helminth eggs, although they are usually much larger than the eggs of most helminth species.

Figure B: Plant material in an iodine-stained concentrated wet mount of stool. This material can be confused for a hookworm egg. Image courtesy of the Alaska State Public Health Laboratory.

Figure C: Plant hair in a concentrated wet mount of stool. Plant hairs can be common in stool and may be confused for the larvae of hookworm or Strongyloides stercoralis. However, they are often broken at one end, have a refractile center and lack the strictures seem in helminth larvae (esophagus, genital primordium, etc).

Figure D: Plant hair in a concentrated wet mount of stool. Plant hairs can be common in stool and may be confused for the larvae of hookworm or Strongyloides stercoralis. However, they are often broken at one end, have a refractile center and lack the strictures seem in helminth larvae (esophagus, genital primordium, etc).
Artifacts in acid-fast stained stool specimens.

Figure A: Yeast in an acid-fast stained stool specimen. These may be confused for the oocysts of Cryptosporidium sp. Images courtesy of the Arizona State Public Health Laboratory.

Figure B: Yeast in an acid-fast stained stool specimen. These may be confused for the oocysts of Cryptosporidium sp. Images courtesy of the Arizona State Public Health Laboratory.

Figure C: Fungal element in an acid-fast stained stool specimen. Such objects may be confused for the oocysts of Cryptosporidium spp. Images courtesy of the Georgia State Public Health Laboratory.

Figure D: Fungal element in an acid-fast stained stool specimen. Such objects may be confused for the oocysts of Cryptosporidium spp. Images courtesy of the Georgia State Public Health Laboratory.

Figure E: Object, probably fungal, in an acid-fast stained stool specimen. Such objects may be confused for the oocysts of Cyclospora spp.

Figure F: Object, probably fungal, in an acid-fast stained stool specimen. Such objects may be confused for the oocysts of Cyclospora spp.
Miscellaneous artifacts in stool.

Figure A: Unknown object in a concentrated stool specimen. This object looks like the egg of Hymenolepis but lacks refractile hooks and the polar filaments seen in H. nana.

Figure B: Unknown objects in a formalin-concentrated stool specimen. Although these objects do not specifically resemble any parasites of humans, their unique appearance may cause the microscopist to take notice.

Figure C: Charcot-Leyden crystals. These crystals are the breakdown products of eosinophils and maybe found in the feces and sputum of people with tissue-invading parasitic infections or various allergic reactions.

Figure D: Charcot-Leyden crystals. These crystals are the breakdown products of eosinophils and maybe found in the feces and sputum of people with tissue-invading parasitic infections or various allergic reactions.

Figure E: Diatoms in stool. Diatoms do not specifically resemble any parasites of humans, but their size and shape and apparent structure may cause the microscopist to take notice.

Figure F: Mite egg in a formalin-concentrated stool specimen. Mite eggs are similar to hookworm eggs but are usually larger (but not always). In this specimen, leg buds can be seen in the lower right area of the egg.
Platelets.

Figure A: Platelet in a thick blood smear. The nature of the platelet gives it the appearance of a trypomastigote of Trypanosoma sp.

Figure B: Platelet in a thin blood smear. The nature of the platelet gives it the appearance of a trypomastigote of Trypanosoma sp.

Figure C: Platelets in thin blood smears. The nature of the platelets gives them the appearance of trypomastigotes of Trypanosoma cruzi.

Figure D: Platelets in thin blood smears. The nature of the platelets gives them the appearance of trypomastigotes of Trypanosoma cruzi.
White blood cells.

Figure A: Neutrophil (left) and monocyte (right) in a thin blood smear, stained with Giemsa.

Figure B: Neutrophils in a thin blood smear, stained with Giemsa.

Figure C: Neutrophil in a thin blood smear, stained with Giemsa.

Figure D: Small lymphocyte in a thin blood smear, stained with Giemsa.
Figure E: Small lymphocyte (left) and neutrophil in a thin blood smear, stained with Giemsa.

Figure F: Neutrophil (lower) and lymphocyte (upper) in a thin blood smear, stained with Giemsa.
Miscellaneous blood elements.

Figure A: Unidentified objects (probably fungal) in a thin blood smear, stained with Giemsa. Such objects may be confused for amastigotes of Leishmania or Trypanosoma cruzi, but the lack of a distinct nucleus and kinetoplast should rule-out these parasites.

Figure B: Fungal spore of Helicosporium (or related). Such objects are air-borne contaminants in laboratories and may be mistaken for microfilariae in stained blood smears.

Figure C: Nucleated red blood cell in a thin blood smear, stained with Giemsa. There are several conditions which can cause a premature release of nucleated red blood cells into circulation. Such objects may be confused for schizonts of Plasmodium spp.

Figure D: Nucleated red blood cell in a thin blood smear, stained with Giemsa. There are several conditions which can cause a premature release of nucleated red blood cells into circulation. Such objects may be confused for schizonts of Plasmodium spp.

Figure E: Howell-Jolly bodies in a thin blood smear, stained with Giemsa. Howell-Jolly bodies are inclusion that may be seen in splenectomized patients or patients with an otherwise non-functioning or atrophic spleen, and in patients with severe anemia or leukemia.
Miscellaneous artifacts in tissue.

Figure A: Yeast in a Giemsa-stained tissue biopsy. Such objects may be confused for amastigotes of Leishmania or Trypanosoma cruzi, but the lack of a distinct nucleus and kinetoplast should rule-out these parasites.

Figure B: Seed in an intestinal biopsy specimen. Such object may be confused with parasites, such as intestinal trematodes or Balantidium coli. The boxy, compartmentalized cells are characteristic of plant tissue. Image courtesy of the Children's Hospital of Eastern Ontario, Canada.
Earthworms, horsehair worms and aquatic fly larvae.

Figure A: Earthworms (Lumbricus and related) are commonly sent to the public health laboratories for identification. The presence of setae, segmentation, and a clitellum (red arrow, Figure B) should distinguish them from parasitic helminths. Images courtesy of the Kentucky Department of Health.

Figure B: Earthworms (Lumbricus and related) are commonly sent to the public health laboratories for identification. The presence of setae, segmentation, and a clitellum (red arrow) should distinguish them from parasitic helminths. Images courtesy of the Kentucky Department of Health.

Figure C: Horsehair worms (Gordius and related). Horsehair worms are parasites of insects and may be found in households and end up in toilets. As a result, they are often sent to the public health laboratories for identification. Images courtesy of the Wisconsin State Laboratory of Hygiene.

Figure D: Horsehair worms (Gordius and related). Horsehair worms are parasites of insects and may be found in households and end up in toilets. As a result, they are often sent to the public health laboratories for identification. Images courtesy of the Wisconsin State Laboratory of Hygiene.

Figure E: Aquatic larvae of flies. The free-living aquatic larvae of various flies breed in standing water, including toilets, leading to the misconception they came from stool or urine. The presence of prolegs, a head capsule, breathing tubes (arrow), segmentation and/or setae will usually distinguish them from true parasitic worms.

Figure F: Aquatic larvae of flies. The free-living aquatic larvae of various flies breed in standing water, including toilets, leading to the misconception they came from stool or urine. The presence of prolegs, a head capsule, breathing tubes (arrow, Figure E), segmentation and/or setae will usually distinguish them from true parasitic worms.
DPDx is an education resource designed for health professionals and laboratory scientists. For an overview including prevention and control visit www.cdc.gov/parasites/.
- Page last reviewed: May 3, 2016
- Page last updated: May 3, 2016
- Content source:
- Global Health – Division of Parasitic Diseases and Malaria
- Notice: Linking to a non-federal site does not constitute an endorsement by HHS, CDC or any of its employees of the sponsors or the information and products presented on the site.
- Maintained By:


 ShareCompartir
ShareCompartir